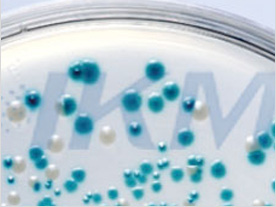

| 序號 | 022200 | |||||||||||||||
| 中文名 | 乳糖蛋白胨培養(yǎng)液 | |||||||||||||||
| 英文名 | Lactose Peptone Broth | |||||||||||||||
| 用途 | 水中多管發(fā)酵法或濾膜法測定大腸菌群 | |||||||||||||||
| 標準 | 國標 | |||||||||||||||
| 配方(g/L) |
|
|||||||||||||||
| 原理 | 蛋白胨、牛肉膏粉提供碳氮源及礦物質(zhì);乳糖是可發(fā)酵的糖類;氯化鈉維持均衡的滲透壓;溴甲酚紫為pH指示劑,酸性呈黃色,堿性呈紫色。 |
|||||||||||||||
| 用法 | 1、稱取本品23g(單料)、或46g(雙料)或69g(三料),加入蒸餾水或去離子水1 L,攪拌加熱煮沸至完全溶解,分裝試管或三角瓶,115℃高壓滅菌20min,備用。作雙料時除蒸餾水或去離子水外其余成分加倍。 2、(1)檢驗生活飲用水國標發(fā)酵法:各取100mL水樣加到50mL三料乳糖蛋白胨培養(yǎng)液中, 共2瓶;各取10mL水樣加到5mL三料乳糖蛋白胨培養(yǎng)液中,共10管。 (2)檢驗生活飲用水衛(wèi)生規(guī)范發(fā)酵法:取10mL水樣接種到10mL雙料乳糖蛋白胨培養(yǎng)液中,取1mL水樣接種到單料乳糖蛋白胨培養(yǎng)液中,另取1mL水樣注入到9mL滅菌生理鹽水中,混勻后吸取1mL(即0.1mL水樣)注入到10mL單料乳糖蛋白胨培養(yǎng)液中,每一稀釋度共接種5管。對已處理過的出廠自來水,需經(jīng)常檢驗或每天檢驗一次,可直接接種5份10mL雙料培養(yǎng)基,每份接種10mL水樣;檢驗水源水時,如污染較嚴重,應加大稀釋度,可接種1,0.1,0.01mL甚至0.1,0.01,0.001。每個稀釋度接種5管,每個水樣接種15管。接種1mL以下水樣時,必須做10倍遞增稀釋后,取1mL接種。每遞增稀釋一次,換用一支1mL滅菌分度吸管。 (3)濾膜法:挑取可疑菌落接種到乳糖蛋白胨培養(yǎng)液中。 3、將接種管放入到培養(yǎng)箱中36±1℃培養(yǎng)24h。 4、觀察結(jié)果。如所有乳糖蛋白胨培養(yǎng)管都不產(chǎn)氣,則可報告為總大腸菌群陰性,如有產(chǎn)酸產(chǎn)氣者,則要進行分離、證實試驗。 |
|||||||||||||||
| 質(zhì)量控制 | 配成的培養(yǎng)基呈紫色透明液體,質(zhì)控菌株接種后于36±1℃培養(yǎng)24h,結(jié)果如下:
|
|||||||||||||||
| 相關(guān)培養(yǎng)基 | ||||||||||||||||
| 圖片 |
|
|||||||||||||||
| 發(fā)布時間 | 2019-05-29 |